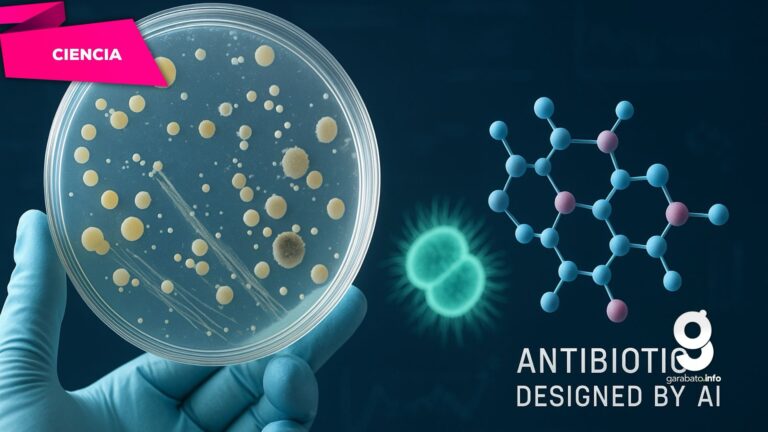

Cambridge, Massachusetts.— Investigadores del Instituto Tecnológico de Massachusetts (MIT) han aplicado algoritmos de inteligencia artificial generativa para diseñar nuevos antibióticos capaces de combatir infecciones resistentes, como la gonorrea y el Staphylococcus aureus resistente a meticilina (MRSA).
El equipo desarrolló más de 36 millones de estructuras químicas teóricas empleando modelos generativos, posteriormente filtradas mediante computación para evaluar su potencial antimicrobiano. Las moléculas más prometedoras, estructuralmente distintas a los antibióticos existentes, mostraron mecanismos novedosos de acción, probablemente alterando las membranas bacterianas.
Entre los compuestos sintetizados, dos—denominados NG1 y DN1—se destacaron por su efectividad en modelos celulares y en ratones. NG1 resultó eficaz contra la gonorrea resistente; DN1 logró eliminar MRSA en infecciones cutáneas en animales. El mecanismo de acción parece involucrar la interrupción de la síntesis o integridad de la membrana bacteriana, lo que les permite actuar con eficacia sobre cepas resistentes.
El profesor James Collins, líder del estudio, subraya el potencial de esta estrategia: “La IA permite explorar espacios químicos mucho más amplios que antes eran inaccesibles”, lo que abre nuevas vías en el desarrollo de antibióticos. El equipo planea aplicar este enfoque también a otras bacterias peligrosas, como Mycobacterium tuberculosis y Pseudomonas aeruginosa.
Aunque los hallazgos representan un avance significativo, los investigadores advierten que estos compuestos aún requieren refinamiento y deben atravesar varias fases de ensayos clínicos antes de considerarse para uso humano. La comunidad científica celebra este avance como el posible inicio de una “segunda edad de oro” en el descubrimiento de antibióticos, frente a la creciente amenaza global de la resistencia antimicrobiana.